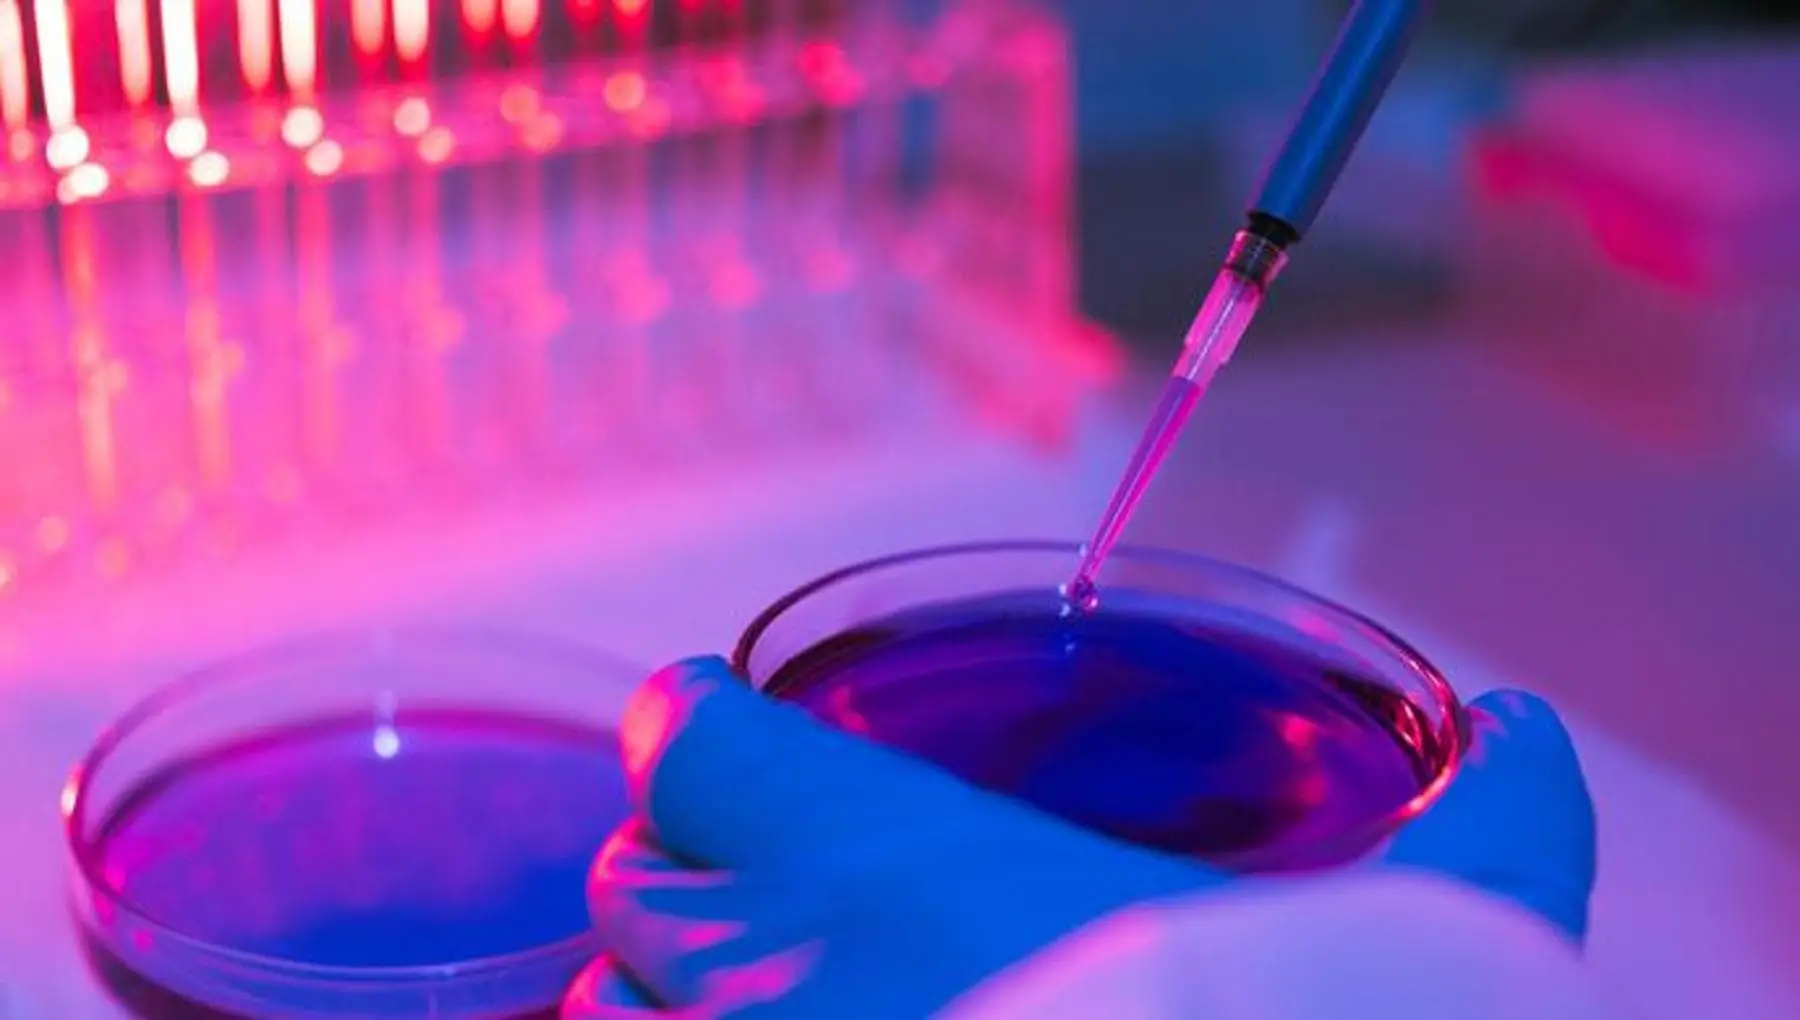

s
Mieloma multiplo, la ricerca accelera: “La guarigione non è più un sogno lontano”
Oggi 21-10-25, 13:39
Per chi convive con il mieloma multiplo, ogni traguardo della scienza è molto più di un dato clinico: è un passo concreto verso una speranza. E …
CONTINUA A LEGGERE

5

0

0









